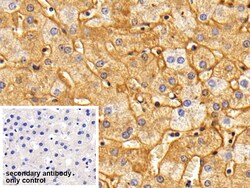
Invitrogen Fibrinogen Polyclonal Antibody, Invitrogen 200 &mu;L; Unconjugated:Antibodies,

missing translation for 'onlineSavingsMsg'
Learn More
Learn More
Invitrogen™ Fibrinogen Polyclonal Antibody, Invitrogen™


Rabbit Polyclonal Antibody
Brand: Invitrogen™ PA5145489
This item is not returnable.
View return policy
Description
Fibrinogen, the precursor of fibrin, is the coagulable protein in the blood plasma of vertebrates. Following vascular injury, fibrinogen is cleaved by thrombin to form fibrin which is the most abundant component of blood clots. Fibrinogen consists as a dimer of 3 pairs of non-identical chains FGA, FGB, and FGG that are cross-linked by disulfide bonds in their N-terminal segments. The molecule has 2 terminal D domains and one central E domain, all three domains are separated when fibrinogen is degradated by plasmin. Mutations in this gene lead to several disorders, including dysfibrinogenemia, afibrinogenemia, and renal amyloidosis.
Specifications
| Fibrinogen | |
| Polyclonal | |
| Unconjugated | |
| FGB | |
| 2510049G14Rik; 3010002H13Rik; A-alpha fibrinogen; Ab1-181; Ab1-216; Ac1-581; Ac1873; AI256424; carboxy-terminal region; ENSMUSG00000059807; epididymis secretory sperm binding protein Li 78p; Fba5e; Fga; Fgb; Fgg; Fib; Fib2; fibg; fibrinogen; fibrinogen A-alpha chain; fibrinogen A-alpha-chain; fibrinogen alpha chain; fibrinogen alpha-E subunit; fibrinogen beta chain; Fibrinogen gamma chain; fibrinogen gamma polypeptide; fibrinogen gamma-B chain; fibrinogen gamma-chain; fibrinogen, A alpha polypeptide; fibrinogen, alpha polypeptide; fibrinogen, B beta polypeptide; fibrinogen, beta polypeptide; fibrinogen, gamma polypeptide; Fibrinopeptide A; Fibrinopeptide B; Gamma'; gamma-fibrinogen; HEL-S-78p; Liver regeneration-related protein LRRG036/LRRG043/LRRG189; MGC119422; MGC119423; MGC119425; PRO2061; testicular tissue protein Li 70; Unknown (protein for MGC:127951) | |
| Rabbit | |
| Antigen affinity chromatography, Protein A | |
| RUO | |
| 100514354, 100626178, 403164 | |
| Store at 4°C short term. For long term storage, store at -20°C, avoiding freeze/thaw cycles. | |
| Liquid |
| Immunohistochemistry (Paraffin), Western Blot, Western Blot | |
| 0.5 mg/mL | |
| PBS with 50% glycerol and 0.05% Proclin 300; pH 7.4 | |
| P14460, P14477 | |
| FGA, FGB, FGG | |
| Native Pig FG protein (Accession #P14460 & P14477). | |
| 200 μL | |
| Primary | |
| Pig | |
| Antibody | |
| IgG |
Product Content Correction
Your input is important to us. Please complete this form to provide feedback related to the content on this product.
Product Title
Spot an opportunity for improvement?Share a Content Correction